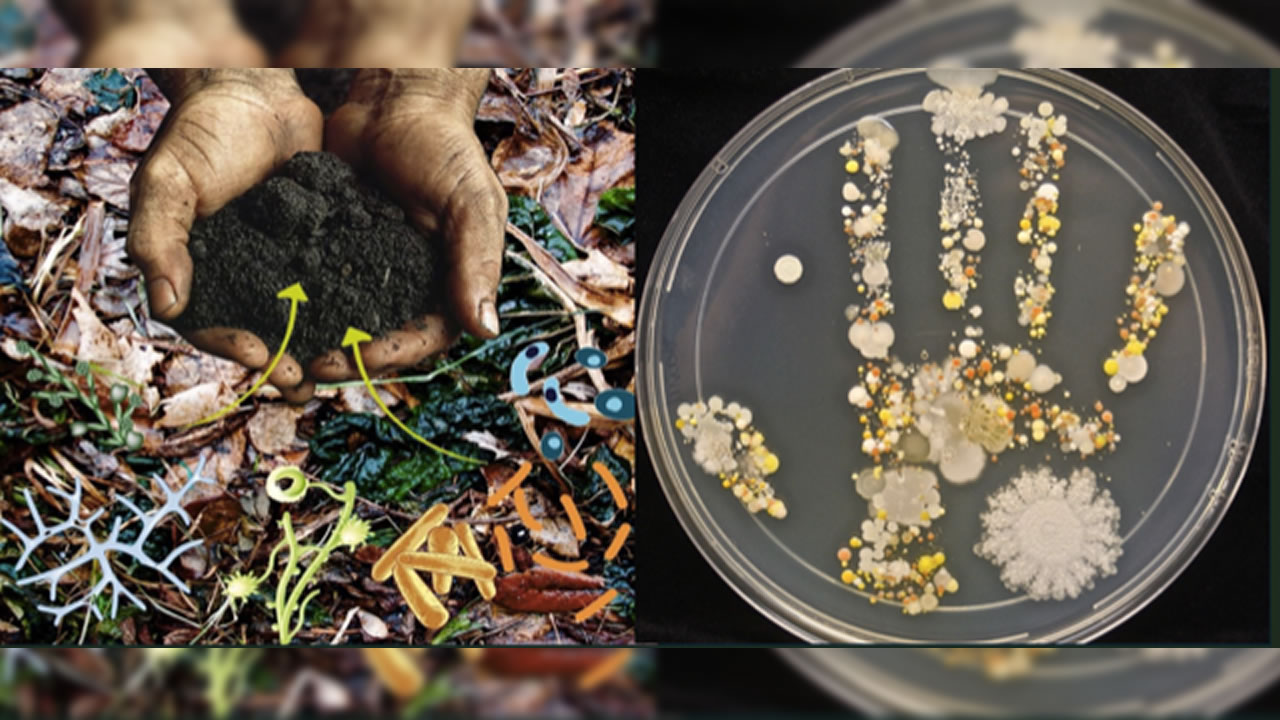

Face à l’urgence climatique et à l’épuisement des terres, la biotechnologie agricole s’impose comme une réponse vivante. Avec l’entreprise malaisienne Vigor Agritech Solutions, découvrons comment microbes et biofertilisants peuvent régénérer nos sols et nourrir l’avenir.
Bactéries, champignons, actinomycètes… sous nos pieds, un monde microscopique s’active sans relâche. Ces microbes du sol ne sont pas de simples organismes invisibles : ils sont les architectes de la fertilité, catalysent la croissance végétale et défendent naturellement les cultures.

Ils décomposent la matière organique, libèrent les nutriments essentiels, améliorent la structure du sol et stimulent les racines des plantes. En restaurant l’équilibre biologique des sols, ils ouvrent la voie à une agriculture plus durable, moins dépendante des intrants chimiques et plus résiliente face aux aléas climatiques.
Comment cela se concrétise-t-il grâce à la biotechnologie agricole ? C’est ce qu’a fait permis l’atelier « Overcoming Challenges of Our Farming Industry Using Biotechnology Approaches », organisé le 25 août 2025 au Voilà Hotel de Bagatelle, à l’initiative de Saheed Thupsee, président de The Aaleemee Society.
L’événement a rassemblé un public varié : petits et grands agriculteurs venus explorer une nouvelle génération de solutions agricoles. L’invitée d’honneur, la Dr Aneeza Soobadar, Ag. Research Manager du Mauritius Sugarcane Industry Research Institute (MSIRI) et de la Mauritius Cane Industry Authority (MCIA), a souligné l’importance de l’innovation pour relever les défis du secteur.
Les participants ont pu découvrir la gamme de produits développés par Vigor Agribiotech Solutions : biofertilisants organiques et liquides, bio-répulsifs et autres formulations de haute qualité à base de micro-organismes indigènes appelés Vigor Indigenous Microbes (VIM). Ces solutions nourrissent les cultures, restaurent la santé des sols et améliorent les rendements de manière durable.
Le CEO de Vigor Agribiotech Solutions, Ezy Yap, a animé deux présentations clés. La première portait sur les approches biotechnologiques pour une agriculture durable, de la régénération des sols à la récolte. La seconde abordait le rôle des microbes bénéfiques comme véritables défenseurs biologiques des cultures. L’atelier a également présenté des études de cas, des résultats de terrain et des applications concrètes de produits brevetés, démontrant leur efficacité dans l’amélioration de la fertilité des sols, le renforcement de la vigueur des plantes et l’augmentation des rendements, même dans des conditions exigeantes.
La session s’est conclue par un temps d’échanges interactifs, permettant aux intervenants et aux agriculteurs de partager expériences et solutions concrètes.

Dinesh Woodun, planteur de légumes : « Le gouvernement doit éveiller les planteurs à une agriculture respectueuse de la nature »
Planteur à Carreau Lalianne, Dinesh Woodun salue la tenue de cet atelier par l’Aaleemee Society et Vigor Agritech Solutions. « Depuis des générations, les planteurs utilisent des produits chimiques pour maximiser leurs rendements, souvent sans mesurer les effets néfastes sur la santé humaine et l’environnement. À ce jour, aucune mesure concrète n’a été prise par les autorités pour encadrer cette pratique ni pour sensibiliser les agriculteurs à une approche plus respectueuse de la nature », déplore-t-il.
Pour lui, cette rencontre est un véritable tournant. « C’est la première fois que je participe à un atelier axé sur les biofertilisants et les solutions biotechnologiques. Ces alternatives peuvent non seulement améliorer la qualité des récoltes mais aussi régénérer les sols appauvris. Ce sont des connaissances que je n’aurais jamais pu acquérir sans ce type d’initiative », confie-t-il. Avec conviction, il insiste : « L’agriculture durable ne doit plus être une option mais une priorité nationale. »
Ezy Yap, CEO de Vigor Agribiotech Solutions : « Nous soutenons la fertilité naturelle des sols »
Parlez-nous des produits développés par Vigor Agribiotech Solutions.
Basée à Johor, au sud de la péninsule malaise, notre entreprise a été fondée en 2009 comme centre de solutions agri-biotechnologiques, spécialisé dans la recherche et le développement microbien ainsi que les applications sur le terrain. Détentrice du statut Bionexus, elle a été primée pour son leadership dans les solutions agricoles basées sur la biotechnologie. Notre ambition est de devenir l’une des entreprises les plus respectées et influentes en Asie dans ce domaine.
Dans notre laboratoire, nous produisons des biofertilisants organiques et liquides, des bio répulsifs et d’autres formulations élaborées à partir de micro-organismes indigènes, appelés Vigor Indigenous Microbes (VIM). Ces microbes bénéfiques nourrissent les cultures, restaurent la santé des sols et protègent les plantes contre les maladies et les stress environnementaux.
Grâce à des méthodes avancées – microbiologie, bio-fermentation et biologie moléculaire – nous sélectionnons les souches locales et étrangères les mieux adaptées aux conditions agricoles pour maximiser les effets synergiques. Nous collaborons avec plus de 5 000 agriculteurs locaux ainsi qu’avec des partenaires au Cambodge et au Vietnam.
Qu’est-ce qui vous a poussé à vous engager dans ce secteur ?
Je suis fils d’agriculteur. Mon père, comme beaucoup d’autres, travaillait dur pour nourrir sa famille dans des conditions difficiles, mais il utilisait des engrais chimiques et pesticides dont il ignorait les dangers. Au fil des années, les rendements baissaient, les sols s’appauvrissaient et les maladies se multipliaient.
Mon père est décédé à 49 ans d’un cancer du foie, que je relie à son exposition prolongée aux produits chimiques. Avant de partir, il m’a dit : « Ne deviens pas agriculteur. » J’étais à ma première année d’ingénierie agricole et biologique.
Après être devenu agronome, j’ai choisi de suivre une voie différente : innover. Ma mission est de développer des solutions biotechnologiques pour réduire la toxicité des sols et la prolifération des maladies, afin de permettre aux agriculteurs de produire des cultures saines pour une agriculture durable.
Depuis 16 ans, nous proposons des biofertilisants et partageons notre expertise avec les universités.
Quelle est la raison de votre déplacement à Maurice ?
Je ne connaissais pas beaucoup l’île. C’est en rencontrant Saheed Thupsee, président de l’Aaleemee Society, lors de son séjour en Malaisie que l’idée a émergé. Nous avons discuté des enjeux de durabilité en agriculture, et il a perçu dans nos solutions une réelle opportunité pour les planteurs mauriciens. Ainsi est né l’atelier de travail visant à présenter nos produits et contribuer à une agriculture plus résiliente et respectueuse de l’environnement à Maurice.
Qu’est-ce qui rend vos produits uniques et innovants ?
Nos formulations exclusives reposent sur sept groupes de micro-organismes bénéfiques, soigneusement sélectionnés pour leurs rôles complémentaires :
Microbes nourriciers : améliorent l’absorption des nutriments par les racines.
Microbes mobilisateurs : facilitent la disponibilité des éléments nutritifs dans le sol.
Microbes de défense : renforcent la résistance des plantes aux maladies et stress environnementaux.
Agents de remédiation : restaurent les sols dégradés.
Stabilisateurs racinaires : favorisent un enracinement profond et durable.
Décomposeurs de matière organique : transforment les résidus végétaux en nutriments.
Microbes synergétiques : assurent l’équilibre global du microbiome du sol.
Cette approche permet de nourrir les cultures en profondeur et de soutenir la fertilité naturelle des sols.
Vos biofertilisants remplacent-ils les engrais chimiques ?
Ils ne visent pas à éliminer les engrais chimiques du jour au lendemain, mais à rééquilibrer leur usage de manière durable. Chez Vigor Agribiotech Solutions, nous proposons une approche synergique : nos biofertilisants enrichissent le sol, renforcent le système racinaire et améliorent la santé globale des plantes. Résultat : les engrais chimiques sont mieux absorbés, moins gaspillés et plus efficaces, tout en réduisant progressivement la dépendance aux produits chimiques.
Répondent-ils aux enjeux de sécurité alimentaire ?
Absolument. Nos solutions optimisent la croissance des cultures, régénèrent les sols et restaurent les cycles biologiques essentiels. Elles créent un environnement où les plantes puisent pleinement les nutriments, développent un système racinaire robuste et produisent des récoltes abondantes, contribuant ainsi à la sécurité alimentaire.
La sensibilisation des agriculteurs est-elle importante ?
Oui. Trop d’agriculteurs souffrent en silence, confrontés à des problèmes pour lesquels ils n’ont souvent aucune solution durable. Notre objectif est de les informer, de les accompagner et de leur offrir des alternatives concrètes. Il s’agit aussi de transformer les mentalités, redonner confiance et équiper les planteurs pour une agriculture plus saine et résiliente.
Qu’attendez-vous de cet atelier à Maurice ?
Nous espérons que les autorités et les agriculteurs soutiendront notre initiative verte et faciliteront le partage d’expertise via d’autres ateliers et la distribution de nos produits, en partenariat avec l’Aaleemee Society. Ce partenariat crée un pont entre recherche, innovation et besoins réels des agriculteurs.
Lors de notre visite, nous avons rencontré des planteurs, testé nos produits sur plusieurs plantations, et collaborons avec l’Université de Maurice pour identifier les micro-organismes présents dans les sols afin de développer des biofertilisants sur mesure adaptés aux spécificités locales.
Saheed Thupsee, président de The Aaleemee Society : « Il est impératif de venir en aide aux planteurs »
Pourquoi cet atelier a-t-il été organisé à Maurice ? Pour Saheed Thupsee, travailleur social depuis 26 ans, la motivation est claire : aider les petits planteurs. « Je voyage régulièrement en Asie dans le cadre de mes fonctions auprès du gouvernement malaisien, notamment pour la Malaysian Trade Development Authority. Lors de mes déplacements, je participe à des foires technologiques pour découvrir des innovations agricoles », explique le président de l’Aaleemee Society.
L’année dernière, il a rencontré Ezy Yap, CEO de Vigor Agritech Solutions en Malaisie. Constatant la dépendance des planteurs mauriciens aux produits chimiques et les sols appauvris qui en résultent, Saheed Thupsee a invité l’entreprise malaisienne à Maurice pour proposer une alternative durable : les biofertilisants. « Avec le changement climatique et la recrudescence des maladies agricoles, il est impératif de soutenir les planteurs, petits ou grands, en particulier ceux cultivant la canne à sucre ainsi que les légumes et fruits. »
Ses observations sur les pratiques agricoles au Cambodge, au Vietnam, en Malaisie et en Inde l’ont convaincu qu’il fallait changer d’approche. C’est ainsi que l’Aaleemee Society a signé un protocole d’accord avec Vigor Agritech Solutions pour organiser une série de workshops destinés à renforcer les compétences des agriculteurs mauriciens. Lors de son prochain voyage en Malaisie, prévu le 15 septembre, l’Aaleemee Society recevra un appareil de test de sol de Vigor Agritech Solutions pour aider les planteurs à évaluer la qualité de leurs terres. « Nous avons déjà distribué des kits de deux litres de biofertilisants pour des essais sur différents terrains. Si les résultats sont concluants, nous importerons les produits à Maurice. L’Aaleemee Society jouera le rôle de facilitateur pour rendre ces solutions accessibles à tous », précise-t-il.
 J'aime
J'aime














